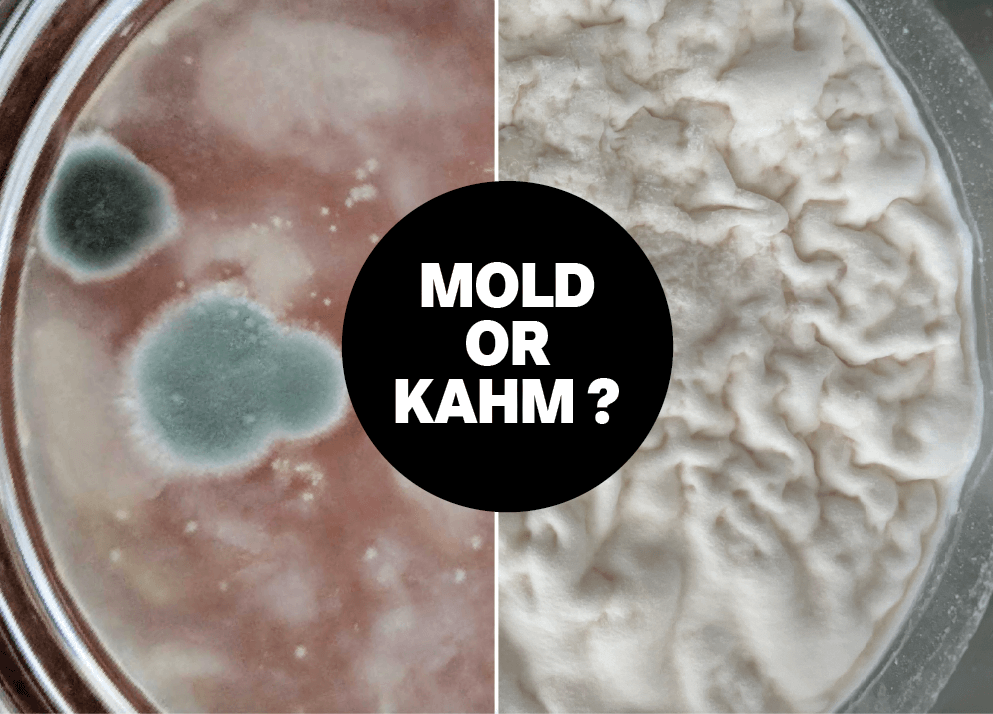
Imagen dividida: la izquierda muestra moho verde difuso, la derecha muestra levadura kahm en un tarro de cristal, con el texto ¿Moho o Kahm? en el centro.

Todos los Articulos -

Cómo hacer
El Secreto de tu Cuerpo al Descubierto: Entrevista a una Dietista sobre Microbiota y Microbioma
Descubre el secreto de tu salud intestinal. Una dietista experta revela qué son la microbiota...
Leer más
Fermentación de verduras y frutas
Zanahorias Fermentadas: La Receta de Ensalada de Zanahoria
Descubre cómo preparar una deliciosa y crujiente ensalada de zanahorias fermentadas. Una receta probiótica que...
Leer más
Kéfir
Kéfir de Leche con Dátiles y Sésamo: El Superalimento Proteico que Haces en Casa
Descubre cómo transformar tu kéfir de leche en un superalimento proteico con dátiles y sésamo....
Leer más
Fermentación de verduras y frutas
Remolacha Fermentada: La Guía Definitiva para Crear un Superalimento en Casa
Descubre el poder de la remolacha fermentada. Una guía con receta para potenciar tu salud,...
Leer más
Fermentación de verduras y frutas
Receta de Kimchi Casero con pasta coreana: La Guía Definitiva para un Sabor Auténtico
Descubre cómo hacer kimchi casero auténtico con nuestra receta fácil. Usa pasta gochujang para un...
Leer más
Fermentación de verduras y frutas
8 Platos con Kimchi que Revolucionarán tu Cocina - Más Allá de Comerlo a Secas
¿Tienes un bote de kimchi en la nevera y no sabes qué hacer? Descubre 8...
Leer más
Fermentación de verduras y frutas
Higos Fermentados en Salmuera: La Receta Probiótica que Transformará tu Despensa
Descubre cómo transformar tus higos en un manjar probiótico. Aprende a fermentar higos en salmuera...
Leer más
Cómo hacer
El Secreto de los Alimentos Fermentados: Descubre los Tipos de Fermentación que Transformarán tu Salud
Descubre los secretos de los alimentos fermentados. Explora los tipos de fermentación, desde el kéfir...
Leer más
Kéfir de Agua
Refrescos Caseros con Kéfir de Agua: Los Sabores Estrella de la Temporada
Descubre cómo hacer refrescos probióticos y deliciosos en casa con kéfir de agua. Te damos...
Leer más
Kéfir de Agua
Receta de Sidra de Kéfir de Agua y Manzana: Tu Bebida Probiótica Casera
Descubre cómo hacer una sidra de kéfir de agua con manzana: una bebida probiótica, burbujeante...
Leer más
Kombucha
Chupito de Jengibre y Kombucha: Tu Dosis Diaria de Energía y Defensas
Descubre cómo preparar un potente chupito de jengibre y kombucha. Una dosis de energía natural...
Leer más
Cómo hacer
El SCOBY de Kombucha: La Guía Definitiva para Entenderlo y Cuidarlo
Descubre qué es un SCOBY, cómo funciona y cómo cuidarlo. La guía definitiva para hacer...
Leer más
Kombucha
Mocktail de Kombucha y Fresas Fermentadas: La Receta Más Chic y Refrescante del Verano
Descubre cómo preparar el mocktail de verano definitivo. Una receta con kombucha casera y fresas...
Leer más
Elaboración de queso
Tiramisú con Queso de Kéfir: La Receta Cremosa y Saludable que no Esperabas
¿Un tiramisú cremoso, sin gluten y bajo en azúcar? Descubre cómo transformar tu kéfir de...
Leer más
Recetas
Kombucha de Saúco y Guinda: La Receta para un Verano Refrescante
Transforma tu kombucha casera en una bebida floral y chispeante. Descubre la receta fácil de...
Leer más
Cómo hacer
Cómo Hacer Kombucha en Casa: La Guía Definitiva para Principiantes
Descubre cómo hacer kombucha casera paso a paso. Nuestra guía definitiva te enseña la primera...
Leer más
Kéfir
¿El Kéfir Tiene Gluten? La Guía Definitiva de Fermentados para una Dieta Segura
¿El kéfir tiene gluten? Descubre por qué los fermentados son clave en tu dieta sin...
Leer más
Vida Saludable
Revitalízate esta Primavera: 5 Razones Consumir Alimentos Fermentados
Descubre cómo los alimentos fermentados pueden transformar tu salud. Potencia tu detox de primavera, refuerza...
Leer más
Cómo hacer
Nódulos de Kéfir: El Corazón Vivo que Transforma la Leche
Descubre el secreto de los nódulos de kéfir, el corazón vivo de tu kéfir casero....
Leer más
Cómo hacer
Consejos para conservar tus fermentos durante meses: Realzando Sabores con Seguridad del proceso
Descubre los secretos para conservar tus fermentos durante meses. Domina el almacenamiento y garantiza un...
Leer más
Fermentación de verduras y frutas
Guía para Fermentar Frutas de Otoño: 6 Tesoros Llenos de Probióticos
Descubre cómo fermentar las mejores frutas de otoño. Transforma manzanas, peras y ciruelas en delicias...
Leer más
Fermentación de verduras y frutas
Mix de Verduras Encurtidas: Tu Receta para Fermentar en Casa
Descubre cómo preparar un delicioso mix de verduras encurtidas en casa. Una receta fácil para...
Leer más
Fermentación de verduras y frutas
Guía Completa para Fermentar Verduras de Otoño: Beneficios, Técnicas y Consejos Prácticos
Aprende a fermentar verduras de otoño en casa y potencia sus beneficios probióticos. Descubre técnicas...
Leer más
Kéfir
Kéfir de Agua: La Guía Definitiva para Dominarlo en Casa
Descubre el kéfir de agua: la bebida probiótica refrescante. Aprende a prepararla en casa, conoce...
Leer más
Kéfir
Transforma tu Kéfir de Agua: 3 Recetas Infalibles para Vencer la Sed
¿Harto del agua? Descubre 3 recetas espectaculares con kéfir de agua para crear bebidas probióticas,...
Leer más
Cómo hacer
Uy, ¡Que calor...! - Como proteger nuestros fermentos cuando las temperaturas suben
¿El calor del verano arruina tus fermentos? Domina la temperatura y protege tu kéfir, kombucha...
Leer más
Cómo Hacer
Fermentar o Encurtir: una guía sencilla para entender la diferencia
¿Fermentar o encurtir? Descubre las diferencias clave, los beneficios para tu salud intestinal y por...
Leer más
Kéfir
Fermentar en casa: ¿tapa abierta o cerrada? El papel crucial del aire
¿Tapa abierta o cerrada? Descubre el papel del aire en la fermentación y aprende a...
Leer más
Fermentación de verduras y frutas
Ha llegado la Primavera y con ella Verduras Frescas
Descubre cómo fermentar las verduras de primavera. Te enseñamos recetas fáciles para espárragos y rábanos...
Leer más
Cómo Hacer
Kombucha sin Fin: Domina la Fermentación Continua
¿Quieres tener kombucha siempre lista? Descubre el método de fermentación continua y disfruta de tu...
Leer más
Kéfir
La revolución sostenible empieza en tu cocina: el poder de la fermentación
¿Quieres una vida más eco-friendly? Descubre cómo la fermentación en casa reduce el desperdicio de...
Leer más
Cómo hacer
El Secreto del Azúcar en tus Fermentados: De Enemigo a Aliado Imprescindible
Descubre por qué el azúcar es el aliado secreto de tu kéfir y kombucha y...
Leer más
Kombucha con Alcohol: Una estimulante Variante de una de las bebidas fermentadas más disfrutadas!
¡Atención a todos los aficionados a las bebidas tradicionales que aportan salud! Presentamos la kombucha...
Leer más
masa madre
Cómo Amasar y hacer Pan de Masa Madre Puede Transformar tu Bienestar: Un Ritual de Relajación y Paciencia
Descubre los beneficios de hacer pan de masa madre. Relájate y mejora tu bienestar con...
Leer más
Cómo hacer
Nódulos de kéfir: ¿el tamaño importa?
¿Te preocupa el tamaño de tus nódulos de kéfir? Descubre si realmente importa y cómo...
Leer más
Cómo hacer
¿Como Elegir el Té Perfecto para tu Kombucha?
Descubre qué té usar para tu kombucha. Guía completa sobre té negro, verde, blanco e...
Leer más
kefir
El Poder Proteico de los Alimentos Fermentados
Al comenzar un nuevo año, muchos se embarcan en el camino hacia un estilo de...
Leer más
Elaboración de queso
Fermentalo, cuelalo, saborealo... - Queso de Kéfir Casero, un Manjar Probiótico
Descubre cómo transformar tu kéfir de leche en un cremoso queso casero. Una receta fácil...
Leer más
Vida Saludable
Kombucha: Mitos y Verdades al Descubierto
Desmontamos los mitos más comunes sobre la kombucha y te contamos la verdad sobre el...
Leer más
Fermentación de verduras y frutas
Aprovecha Tu Cosecha de Otoño
El otoño te da una cosecha abundante. Aprende a fermentar verduras y frutas con recetas...
Leer más
Vida Saludable
La vuelta al mundo a través del pan de masa madre
Embárcate en un viaje global y descubre los secretos del pan de masa madre: desde...
Leer más
Guía Práctica
Moho vs. Levadura de Kahm: La Guía Definitiva para Salvar tus Fermentos
¿Ves una capa extraña en tu kéfir o kombucha? Aprende a distinguir la inofensiva levadura...
Leer más
Masa Madre
Brownies de Masa Madre: La Receta para un Resultado Jugoso y Adictivo
Descubre la receta definitiva para unos brownies de masa madre increíblemente jugosos y con un...
Leer más
Cómo hacer
Receta de Pan de Espelta con Masa Madre: La Guía Sencilla para un Resultado Perfecto
Descubre cómo hornear un pan de espelta y masa madre irresistible. Sigue nuestra receta paso...
Leer más
Cómo Hacer
Guía de Reactivación: Revive tu Kéfir, Kombucha y Masa Madre Post-Vacaciones
¿Has vuelto de vacaciones y tus fermentos están dormidos? Aprende a reactivar tu kéfir, kombucha...
Leer más
Kéfir
Todo lo que tienes que saber sobre Masa Madre
¿Quieres hacer un pan casero increíble? Descubre qué es la masa madre, cómo crearla desde...
Leer más
Vida Saludable
Fermentación: El Poder Secreto de las Bacterias y Levaduras
Descubre la ciencia oculta tras la fermentación. Entiende el papel de bacterias y levaduras en...
Leer más
Vida Saludable
Combate la Astenia Primaveral: El Poder Secreto de los Alimentos Fermentados
Di adiós a la fatiga primaveral. Descubre cómo los alimentos fermentados y sus probióticos pueden...
Leer más
Cómo
Cómo Convertir a Kombucha en tu Mejor Limpiador Ecológico
Descubre cómo transformar tu kombucha sobrefermentada en un potente limpiador ecológico. Una alternativa natural y...
Leer más
Kefirko
Fermentados: Tu Escudo Natural Contra el Resfriado
¿Cansado de los resfriados de invierno? Descubre cómo los alimentos fermentados como el kéfir y...
Leer más
Cómo Hacer
Fermentar Kombucha en Invierno
¿Tu kombucha se apaga en invierno? Domina la fermentación con frío. Descubre trucos para mantener...
Leer más
Kéfir
¿Cuando es el mejor momento para tomar tu Kéfir de Leche?
¿Kéfir por la mañana, en ayunas o antes de dormir? Descubre el momento ideal para...
Leer más
Estilo de vida saludable
Adiós a los Excesos Navideños: Cómo Resetear tu Digestión con Alimentos Fermentados
Tras los excesos navideños, recupera tu bienestar digestivo. Descubre cómo los alimentos fermentados pueden ser...
Leer másKéfir sin lactosa: Kéfir de leche de coco
¿Has probado alguna vez el kéfir de leche de coco? Puede ser una gran alternativa...
Leer másBatido de kéfir de coco con fresas y plátano
El kéfir de coco hecho con leche de coco es una alternativa fantástica al kéfir...
Leer másKéfir casero rico en vitaminas
El blog Kefirko está dedicado al kéfir casero y a sus beneficios para la salud....
Leer másFermentación del kéfir de agua
El kéfir de agua se elabora con agua, azúcar y nódulos de kéfir. El proceso...
Leer másCómo guardar los nódulos de kéfir cuando te tomas un descanso del kéfir
Los probióticos necesitan prebióticos para crear una microbiota saludable. ¿Haces pausas para preparar y beber...
Leer másComidas con kéfir para un día probiótico
El kéfir es una bebida probiótica con muchos efectos positivos para la salud intestinal y...
Leer másPreparar té de kombucha en casa
El té de kombucha o "té de la vida" es una bebida fermentada elaborada con...
Leer másBolas de queso con hierbas frescas
Si eres un fanático del queso, te encantará esta receta rápida y fácil de bolas...
Leer másBarras de pan de jengibre con glaseado de kéfir
Las barras de pan de jengibre con glaseado de kéfir pueden ser una versión especial...
Leer másBeneficios y sabores de la segunda fermentación
La segunda fermentación es una forma estupenda de potenciar el kéfir casero con nutrientes y...
Leer más¿Qué es el kéfir?
Los probióticos necesitan prebióticos para crear una microbiota saludable. ¿Qué es el kéfir? El kéfir...
Leer másBeneficios de beber kéfir
Los probióticos necesitan prebióticos para crear una microbiota saludable. rico en vitamina B contiene ácido...
Leer más¿Por qué hacer kéfir en casa?
El kéfir es fácil de hacer en casa y más beneficioso para el cuerpo. El...
Leer másLos beneficios del Kefir casero
El kéfir es una bebida espesa elaborada mediante la fermentación de la leche con nódulos...
Leer másEl super batido más delicioso
Batido para cualquier amante de los superalimentos. Este delicioso Super Bowl Smoothie está repleto de...
Leer másEnsalada de primavera con aderezo de kéfir ligeramente picante
Añade especias a tu kéfir para crear un sabroso aderezo de kéfir. El aire es...
Leer másReceta rápida de Panecillos de cebolla con pipas de calabaza
Sólo necesitas 30 minutos para preparar estos deliciosos panecillos de cebolla con pipas de calabaza....
Leer más¿El sabor natural del kéfir de leche no te agrada? ¡Dale sabor!
La bebida fermentada altamente probiótica puede mejorarse aún más Después de las primeras 24 horas...
Leer más¿Nódulos de kéfir o cultivo iniciador? Cuál elegir y por qué
El kéfir, como bebida láctea fermentada, necesita bacterias y otros cultivos para que fermente. La...
Leer másPanna cotta con mango y frambuesas
Panna cotta con mango. No hay nada como un poco de dulzura para alegrar el...
Leer másCómo hacer kéfir en casa
Toma 200-300 ml de kéfir de leche fresco al día (1 taza), puedes añadir un...
Leer másKéfir casero y vitaminas
Los probióticos necesitan prebióticos para crear una microbiota saludable. El blog Kefirko está dedicado al...
Leer másCómo enviar por correo los nódulos de kéfir
¿Has considerado alguna vez enviar por correo los nódulos de kéfir si tienes demasiados? Como...
Leer másPolos probióticos de fruta
Polos de frutas con probióticos hechos con kéfir fresco El verano está aquí y eso...
Leer másKéfir de leche de coco: una alternativa de kéfir sin lactosa
¿Has probado alguna vez el kéfir de leche de coco? Puede ser una gran alternativa...
Leer másDeliciosa Agua de frutas
¡Disfruta de un vaso de agua de frutas! Durante los calurosos días de verano, una...
Leer másBatido de kéfir de coco con fresas y plátano
El kéfir de coco hecho con leche de coco es una alternativa fantástica al kéfir...
Leer másLos favoritos del otoño: Sopa de calabaza con kéfir
Sopa de calabaza con kéfir. El otoño ha caído y también sus colores. Usando su...
Leer másEl kéfir, uno de los alimentos probióticos más potentes
Los probióticos necesitan prebióticos para crear una microbiota saludable. Uno de los datos interesantes sobre...
Leer másNaranjada de kéfir de agua con gas
Naranjada con gas Si te gusta beber kéfir de agua, quizá quieras probar a variarlo...
Leer másEl kéfir casero, rico también en minerales
Los probióticos necesitan prebióticos para crear una microbiota saludable. Como ya sabrás, el kéfir casero...
Leer másAguacate relleno de kéfir y huevo
¿Buscas ideas para una comida rápida o una merienda en la que se puedas utilizar...
Leer másCómo hacer una pausa en la elaboración de kéfir
Los probióticos necesitan prebióticos para crear una microbiota saludable. ¿Haces pausas para preparar y beber...
Leer másKéfir de agua de coco
Lleno de cepas de bacterias que mejoran tu salud intestinal, un gran refresco que puede...
Leer másCómo hacer la segunda fermentación del kéfir
Una vez que te hayas abierto camino en el proceso de elaboración del kéfir y...
Leer másMuffins de chocolate y manzana hechos con kéfir
Muffins de chocolate con manzana. Con los días más fríos y cortos solemos pasar más...
Leer más5 pasos para revivir los nódulos de kéfir de leche
Lo maravilloso de los nódulos de kéfir de leche es su resistencia. Incluso después de...
Leer másBebida probiótica para reforzar la inmunidad de tus hijos
¿Cómo puede una bebida probiótica ayudar al sistema inmunitario de sus hijos? Aunque el invierno...
Leer másPan de kéfir y harina de espelta con semillas
Pan de kéfir con semillas. No te sientas intimidado, no sólo nuestras madres y abuelas...
Leer más¿Cuál es la mejor leche para hacer kéfir?
Tanto si eres un principiante en la elaboración de kéfir de leche como si sólo...
Leer másLa proteína del suero de Kéfir, la bebida de los dioses
El suero de leche es un subproducto que obtenemos al elaborar queso a partir de...
Leer másBrioche hecho con kéfir
El brioche es un bonito y exquisito bollo francés que suele disfrutarse en el desayuno....
Leer más¡Mozzarella casera para cualquier cocinillas!
La mozzarella casera no es algo aterrador y complicado que cualquier cocinero casero no pueda...
Leer másLos probióticos pueden ayudar a controlar la presión arterial
¿Te imaginas controlar la presión arterial alta —hipertensión— con algo tan natural como los probióticos?...
Leer másbebida
La Historia de Kefirko
Kefirko es un kit todo en uno creado para ayudarnos en la tarea de preparar...
Leer másfermentos
¿Qué es el kéfir?
El kéfir es una bebida fermentada repleta de probióticos y otros ingredientes muy beneficiosos para...
Leer másbebida
Prepara Kombucha Casera con el Kefirko
¿Qué es la Kombucha? El té Kombucha o “té de la vida” es una bebida...
Leer másbeneficios
¿Nódulos de kéfir o kéfir en polvo? Cuál elegir y por que
Existen dos tipos diferentes de kéfir, en gránulo o nódulos, o kéfir en polvo. Ambos...
Leer másbebida
Champán para niños
Prepara un delicioso y saludable Champán para niños con kéfir de agua. ¡Ideal para las celebraciones...
Leer másbeneficios
Beneficios de beber kéfir
¿Sabes cuáles son los beneficios que nos aporta el beber kéfir?
Leer más¿Cuál es la dosis diaria recomendada de kéfir?
¿Bebes kéfir todos los días? ¿O sólo bebes una taza de vez en cuando? Mientras...
Leer másTortitas con suero de leche y harina de trigo sarraceno
Esta receta de deliciosas tortitas con suero de leche es una versión especial de las...
Leer másProbióticos y prebióticos: ¿por qué son importantes ambos?
Comer alimentos diversos contribuye a una digestión saludable. Cuando hablamos de probióticos no podemos olvidar...
Leer más¿Pueden los niños beber kéfir casero?
Algunos de mis amigos y colegas tienen hijos que nacieron con alergias y un sistema...
Leer másAlimentos fermentados durante el embarazo y la infancia
Alimentos fermentados: ¿son recomendables para las embarazadas y los bebés? Lo que la madre come...
Leer más4 pasos para preparar la crema de queso de kéfir
¿Es el queso crema algo sin lo que no puedes vivir? Tal vez te preguntes...
Leer másKéfir de agua con violetas dulces: un comienzo perfecto para la primavera
Prepara este delicioso kéfir de agua y disfruta de lo que la naturaleza te ofrece....
Leer másReceta de batido de kéfir de agua con ajo silvestre
El batido de kéfir de agua de ajo silvestre es una bebida refrescante de primavera....
Leer más¿Cuál es el valor nutricional del kéfir casero?
Si bebes kéfir con regularidad, probablemente ya sabes cuál es el valor nutricional general del...
Leer másTarta con kéfir para ocasiones especiales
Se trata de una tarta con kéfir que suele hacerse en ocasiones especiales como la...
Leer másKefir de leche de coco como alternativa al kefir de leche animal
Con infinitas posibilidades, este kéfir de coco sin lactosa es una gran alternativa a los...
Leer másNódulos de kéfir de leche: la fuerza interior
Nódulos de kéfir de leche Los nódulos de kéfir de leche son la fuerza vital...
Leer másCrostini con crema de queso de kéfir y ajo silvestre
Este crostini con crema de queso de kéfir llevará los ingredientes naturales a tu mesa....
Leer másKéfir de agua con lila común para una perfecta bienvenida a la primavera
La lila común perfumada es un bonito arbusto en flor que podemos encontrar en casi...
Leer más5 consejos que pueden ayudar a fermentar los nódulos de kéfir
¿Buscas formas de ayudar a fermentar los nódulos de kéfir? Si no estás satisfecho con...
Leer másHuevos revueltos con cuajada de kéfir y lúpulo silvestre
Los huevos revueltos son frecuentes en la comida cuando queremos un desayuno rico. Junto con...
Leer másBacterias buenas en el kéfir para mejorar la salud intestinal
Las bacterias suelen tener mala fama, pero no toda ella está justificada. De hecho, hay...
Leer másKéfir congelado: ¡tu tipo de helado favorito!
¿Kefir congelado? ¡Qué idea para un refresco! Probablemente ya hayas probado el yogur helado. En...
Leer más¡Batido de kéfir y sandía para los días calurosos de verano!
La sandía suele disfrutarse en los días calurosos de verano. Si quieres utilizarla en una...
Leer másRico queso de kéfir con cebollino
Hacer queso de kéfir a partir de kéfir es una forma estupenda de hacer tu...
Leer másBebida de mango y suero de leche
Esta receta fue preparada por Melanie Reisner-Kollmann de unbeschwert.at. Esto es lo que dijo...
Leer másKéfir de agua con té verde y jengibre
El té verde es excelente para relajarse y combina muy bien con el jengibre, el...
Leer másPesto con albahaca y kéfir casero
¿Eres un fanático de los platos de pasta y siempre buscas ideas interesantes para las...
Leer másNubes de manzana y kéfir sin gluten
Prepara estas nubes de manzana y queso de kéfir sin gluten para conseguir una delicia...
Leer másCrema de queso de kéfir e higos para un sabroso desayuno
Si hay una combinación perfecta, ¡definitivamente se trata de los higos, la crema de queso...
Leer másChapata hecha con kéfir de agua y masa madre
El pan elaborado con kéfir de agua y masa madre es fácil de digerir y...
Leer másBeneficios del kéfir de agua casero
Los "bichos buenos" del kéfir casero siempre han sido buenos para mí y mi intestino,...
Leer másGuía definitiva de regalos de Kefirko para las fiestas
¿Busca ideas de regalo para las fiestas? Estás en el lugar adecuado si quieres hacer...
Leer másSobrefermentación, ¿qué significa y es problemática?
La sobrefermentación es un fenómeno que resulta de una fermentación que duró demasiado tiempo o...
Leer másJabones de kéfir para una piel sana y nutrida
Los alimentos fermentados, como el kéfir casero, pueden beneficiar a la microbiota al mejorar su...
Leer másCómo activar los nódulos de kéfir de agua: guía paso a paso
Si estás buscando consejos sobre cómo activar los nódulos de kéfir de agua, este es...
Leer másSegunda fermentación de kéfir de agua: ¡añade algo de sabor a tu bebida!
La segunda fermentación del kéfir de agua es un proceso que añade más sabor y...
Leer másPan de masa madre: ¡ahora es el momento de hornearlo!
El pan de masa madre se hace sin levadura comprada. Hornear en casa puede ser...
Leer más¿Qué azúcar es mejor para hacer kéfir de agua?
¿Qué azúcar es mejor utilizar para preparar kéfir de agua en casa? El kéfir de...
Leer másKéfir de leche: ¡guía para principiantes de hacer kéfir!
¿Has oído hablar de esta bebida similar al yogur, pero con muchas más bacterias vivas?...
Leer másProblemas con los nódulos de kéfir de agua y cómo solucionarlos
Independientemente de si eres un principiante de la fermentación o si haces kéfir con regularidad,...
Leer más
Cuando dejamos los nódulos de kéfir en la nevera...
Nos pasa a todos, dejamos los nódulos en la nevera durante un periodo de tiempo...
Leer más
¿Es bueno el kéfir de leche para perder peso?
El kéfir de leche es una bebida fermentada rica en proteínas. Es bajo en calorías,...
Leer más
Segunda fermentación de kéfir de agua con té de rosa mosqueta
La segunda fermentación del kéfir de agua con rosa mosqueta es una forma estupenda de...
Leer más
Queso de kefir con cayena: ¡hazlo picante!
Puedes preparar un delicioso queso de kéfir con pimienta de cayena con sólo unos pocos...
Leer más
¿Cuál es el valor de pH óptimo de las bebidas fermentadas?
Con la escala de pH puedes determinar el valor actual del pH de tu fermento....
Leer más
Aumenta las burbujas en tu kéfir de agua
¿Deseas que tu kéfir de agua tenga más burbujas? En esta entrada del blog, describimos...
Leer más
Kéfir vegano: cuando buscas un kéfir sin lactosa
El kéfir vegano se prepara con nódulos de kéfir de leche y leche vegana. El...
Leer más
¿Cómo elaborar kombucha para que tenga gas?
¡Entre las bebidas fermentadas, la kombucha con gas es una de las más refrescantes y...
Leer más
Cómo puedes beneficiarte de comer verduras fermentadas
¿Todavía no te convence la idea de fermentar las verduras? Este artículo puede hacerte cambiar...
Leer másMostrando 12 de 149 artículos

